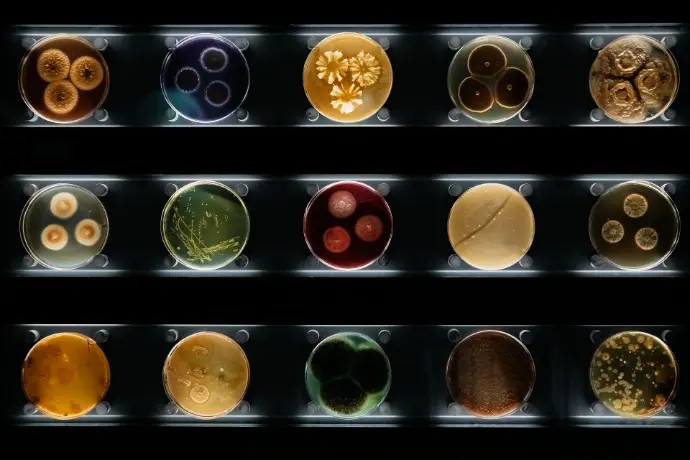
Différents types de bactéries, de moisissures et de champignons dans les boîtes de Petri

iSpyBio is a scientific platform dedicated to organizing and structuring biological research information across the life sciences. Our mission is to facilitate access to validated scientific resources, experimental references, and molecular research content within a clear and structured environment. The platform is designed to support researchers seeking contextualized biological information linked to experimental evidence and peer-reviewed literature.
Explore Scientific Resources
Search and navigate across interconnected scientific domains
Scientific Focus Areas
Molecular Targets & Antibody Resources
Explore detailed scientific information on antibodies, protein targets, and gene-associated markers. Each entry highlights its molecular relevance, biological role, experimental context, and practical applications, helping researchers quickly understand how each entity is studied and validated.
Specimen & Biomarker Insights
iSpyBio provides curated information on biological specimens, covering tissue origin, species relevance, associated molecular markers, and research application context. Common laboratory applications include Western Blot (WB), Immunohistochemistry (IHC), ELISA, and Immunofluorescence (IF).
This structured approach helps researchers quickly understand how molecular targets are linked to biological specimens and validated through experimental methods.

Experimental Documentation
iSpyBio organizes experimental figures, validation records, and research-linked evidence alongside their corresponding molecular targets. By connecting documentation with scientific context, the platform helps researchers interpret laboratory findings clearly and understand methodological relevance.

Research Publications
iSpyBio cross-references peer-reviewed literature with specific molecular targets and biological pathways. Publications are organized to provide clear navigation through research findings, molecular mechanisms, experimental techniques, and biological applications, supporting comprehensive scientific exploration in a single, connected view.

Integrated Scientific Context
iSpyBio goes beyond isolated data points by connecting molecular targets, experimental methods, biological specimens, publications, and application insights.
This integrated framework allows researchers to explore and analyze information across multiple disciplines:
Designed for the Scientific Community iSpyBio supports:
- Academic research laboratories
- Biotechnology researchers
- Translational science initiatives
- Pharmaceutical development teams
- Diagnostic research projects
The platform prioritizes clarity, structure, and scientific relevance. Its purpose is to assist researchers in navigating complex biological information with consistency and transparency.
Research Applications
iSpyBio’s structured scientific content supports a wide range of research activities, including:
Target validation studies :Understanding and confirming molecular targets.
Biomarker discovery research : Identifying biological indicators of disease or response.
Antibody characterization :Evaluating antibody specificity and performance.
Assay development : Designing and optimizing laboratory tests.
Molecular pathway analysis : Exploring biochemical and signaling pathways.
Preclinical investigation : Supporting early-stage research and experimental studies.
By presenting information in a neutral, evidence-based structure, iSpyBio helps researchers make informed decisions and conduct rigorous scientific evaluation.
Platform Evolution
iSpyBio continues to evolve with a focus on strengthening structured scientific access and interdisciplinary connectivity within the life sciences ecosystem. Long-term objectives include expanded research integration capabilities and enhanced support for scientific resource discovery, while maintaining a clear and evidence-based positioning.
Frequently asked questions
Here are some common questions about our company.
iSpyBio structures content by linking molecular targets, biological specimens, experimental methods, and publications. This approach helps researchers explore connections and understand context across life sciences.
Yes. The platform provides curated information on antibodies, protein targets, and biomarkers, including experimental context, tissue and species relevance, and applicable laboratory techniques.
Yes. The platform provides curated information on antibodies, protein targets, and biomarkers, including experimental context, tissue and species relevance, and applicable laboratory techniques.
iSpyBio is designed for researchers, academic laboratories, biotechnology teams, and translational science initiatives seeking structured, reliable scientific information.